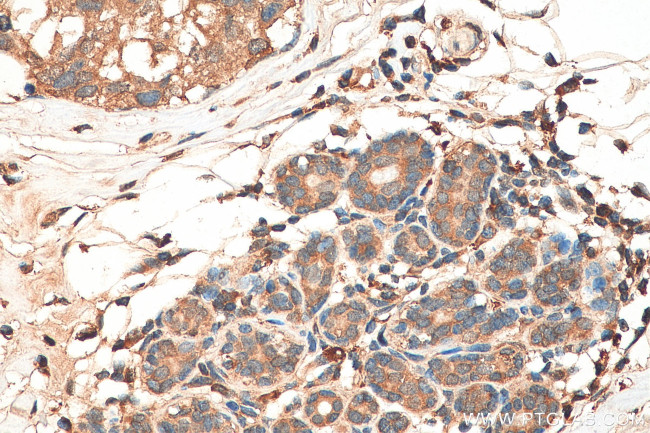
PTPN13 Antibody in Immunohistochemistry (Paraffin) (IHC (P))
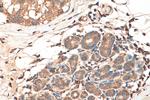
PTPN13 Antibody in Immunohistochemistry (Paraffin) (IHC (P))

Search
Proteintech
PTPN13 Polyclonal Antibody
{{$productOrderCtrl.translations['antibody.pdp.commerceCard.promotion.promotions']}}
{{$productOrderCtrl.translations['antibody.pdp.commerceCard.promotion.viewpromo']}}
{{$productOrderCtrl.translations['antibody.pdp.commerceCard.promotion.promocode']}}: {{promo.promoCode}} {{promo.promoTitle}} {{promo.promoDescription}}. {{$productOrderCtrl.translations['antibody.pdp.commerceCard.promotion.learnmore']}}
产品信息
25944-1-AP
种属反应
宿主/亚型
分类
类型
抗原
偶联物
形式
浓度
规格
纯化类型
保存液
内含物
保存条件
运输条件
产品详细信息
Immunogen sequence: MHVSLAEAL EVRGGPLQEE EIWAVLNQSA ESLQELFRKV SLADPAALGF IISPWSLLLL PSGSVSFTDE NISNQDLRAF TAPEVLQNQS LTSLSDVEKI HIYSLGMTLY WGADYEVPQS QPIKLGDHLN SILLGMCEDV IYARVSVRTV LDACSAHIRN SNCAPSFSYV KHLVKLVLGN LSGTDQLSCN SEQKPDRSQA IRDRLRGKGL PTGRSSTSDV LDIQKPPLSH QTFLNKGLSK SMGFLSIKDT QDENYFKDIL SDNSGREDSE NTFSPYQFKT SGPEKKPIPG IDVLSKKKIW ASSMDLLCTA DRDFSSGETA TYRRCHPEAV TVRTSTTPRK KEARYSDGSI A (1-350 aa encoded by BC140777)
靶标信息
The protein encoded by this gene is a member of the protein tyrosine phosphatase (PTP) family. PTPs are signaling molecules that regulate a variety of cellular processes including cell growth, differentiation, mitotic cycle, and oncogenic transformation. This PTP is a large intracellular protein. It has a catalytic PTP domain at its C-terminus and two major structural domains: a region with five PDZ domains and a FERM domain that binds to plasma membrane and cytoskeletal elements. This PTP was found to interact with, and dephosphorylate, Fas receptor and IkappaBalpha through the PDZ domains. This suggests it has a role in Fas mediated programmed cell death. This PTP was also shown to interact with GTPase-activating protein, and thus may function as a regulator of Rho signaling pathways. Four alternatively spliced transcript variants, which encode distinct proteins, have been reported.
仅用于科研。不用于诊断过程。未经明确授权不得转售。
生物信息学
蛋白别名: DKFZp686J1497; FAP-1; Fas-associated protein-tyrosine phosphatase 1; hPTPE1; protein tyrosine phosphatase, non-receptor type 13 (APO-1/CD95 (Fas)-associated phosphatase); Protein-tyrosine phosphatase 1E; Protein-tyrosine phosphatase PTPL1; PTP-BAS; PTP-E1; Tyrosine-protein phosphatase non-receptor type 13
基因别名: FAP-1; hPTP1E; PNP1; PTP-BAS; PTP-BL; PTP1E; PTPL1; PTPLE; PTPN13
UniProt ID: (Human) Q12923
Entrez Gene ID: (Human) 5783